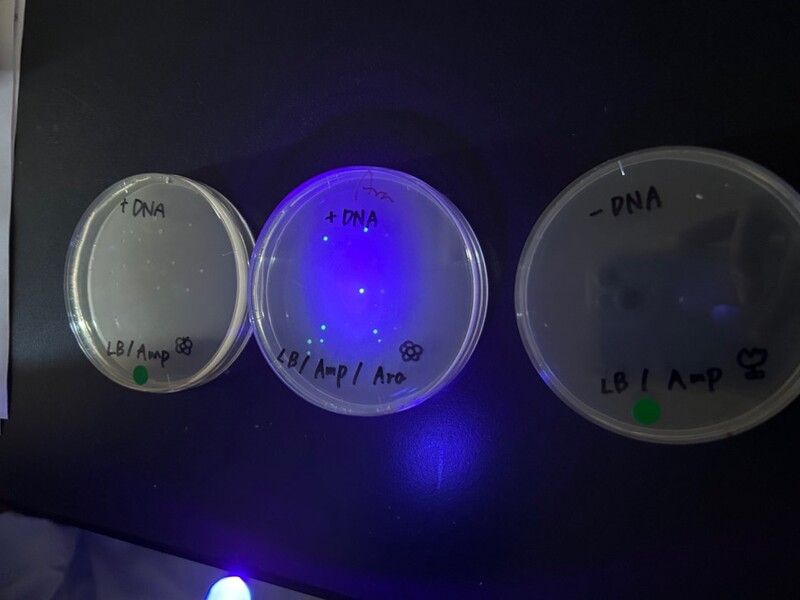

高校生が学会発表!探究が進路を切り拓く―中村学園で育つ“問い”の力
近年、全国の教育現場で注目されている「探究学習」。単に知識を詰め込むのではなく、自ら問いを立て、答えを探す力を育てる取り組みです。
中村学園女子中学校・高等学校(福岡市)は、そうした探究学習をいち早く実践してきた学校のひとつ。そんな同校を訪ねると、高校生たちが学会で研究発表に挑戦するなど、教室の枠を超えた“本物の学び”に取り組む姿がありました。

学校の枠を飛び出し、高校生が学会で研究発表

普段は生物の飼育や実験に取り組む中村学園女子高校の化学・生物部。テーマを決めて本格的な実験・観察にも挑戦しています。
2024年度には、生徒たちが全国から研究者や学生が集まる大規模な学会「日本分子生物学会 年会」に初めて参加しました。

発表内容は、LDLコレステロールと遺伝子の関係性や、食品成分がもたらすパーキンソン病予防効果など、いずれも高校の枠を超えた本格的なものばかり。
高校生部門の事前審査を通過し、生徒6人が専門家らの前で堂々と研究成果を発表しました。
発表した田中凜桜さんは「研究者に憧れはあったけれど、行動には移せずにいました。高校生でも学会で発表できると知って驚きましたし、『生物学が好き、研究を続けたい』という気持ちがはっきりしました」と振り返ります。

発表後のポスターセッションでは、大学・研究機関の専門家からの質問にも自信を持って答え、多くのフィードバックを受け取るなど、実りある経験となりました。 顧問の武宮妙貴先生は「最初は不安そうだった生徒たちが、試行錯誤しながら自分たちで発表を形にしていく姿に成長を感じました」と語ります。
小さな興味が、未来を選ぶ力にも
化学・生物部の活動は、生徒の将来にも影響を与えています。
「前よりも生物にもっと興味を持つようになりました」と話す能美穂夏さんは、部活動での探究を通して生物への興味が深まり、進路を決めたといいます。

また、今年度は化学分野での新たな研究もスタート。実験中に生徒たちが感じた「この反応、どうしてこうなるのだろう?」という素朴な疑問が、そのまま研究テーマへと発展しました。
生徒たちは自ら論文や文献を探し、学外の大学研究室にも協力を仰ぎながら、学会発表を目指して実験や考察を重ねています。
高校×大学のシームレスな学び
こうした探究活動の背景には、中村学園ならではの「高大連携」の取り組みがあります。化学・生物部では、隣接する中村学園大学の研究室を訪れ、高校にはない実験機器や分析技術を体験。教授や大学生のアドバイスを受けながら、自らの“問い”を掘り下げる経験を積んでいます。
「これってどうして?」から始まる、深く考える力

学会発表に向けて実験や観察を進めるなかで、生徒たちには自然と“問い” が芽生えていきました。「授業で習ってないことばかりでしたが、一つずつ理解しながら『こういうことなのかな』と考えて進めていきました」と前川風花さん。
誰かに与えられるのではなく、自分で考え、調べ、行動する。こうした経験を通じて、生徒たちの「学ぶ姿勢」は着実に育まれています。
「新しいことに挑戦し、困難にぶつかったときに“どう解決するか”を学ぶ─。彼女たちの姿から、こうした経験を通して、将来のさまざまな場面でも目標に向かって自分で動ける力を身につけていくのだと感じました」と武宮先生。
また、令和8年度より、高校3年生の後期から「科目等履修生制度」を利用して高校と大学の学びが自然とつながる仕組みが整っています。
やってみたい!が広がる特別講座「N.Box」
R8年度の共学化に合わせて、中村学園では、生徒たちの興味関心の芽を育み、視野を広げるため、現在のユニーク講座を発展させた特別講座「N.Box(ナカムラ・ボックス)」を実施する予定です。
プロジェクションマッピングや食品添加物の実験、SDGsに関するワークショップなど、中学・高校や教科の枠を超えた内容に触れることができます。
教科の枠にとらわれないテーマで、中学生・高校生が「やってみたい!」と思えるきっかけをつくることを目的としたプログラムです。
2026年男女共学化、「自分らしく学べる学校」へ
2026年4月入学生より、中村学園女子中学校・高等学校は男女共学になります。これまで培ってきた探究型の学びをベースに、性別や得意不得意を問わず、誰もが“自分らしく学べる学校”として新たな一歩を踏み出します。
「生徒の“やりたい”を尊重し、それをサポートできる学校にしていきたいと考えています。部活に限らず、どんな挑戦もできる環境を整えていきたいですね」と武宮先生は語ります。
中村学園が大切にしているのは、「自分の目で見て、考え、行動できる人」を育てること。探究活動や高大連携を通して、知識を得るだけでなく、学びを“自分ごと”として捉える力を育んでいます。
そして「学びが面白い」と感じるその瞬間は、生徒たちの未来を切り拓く原動力になっているのです。